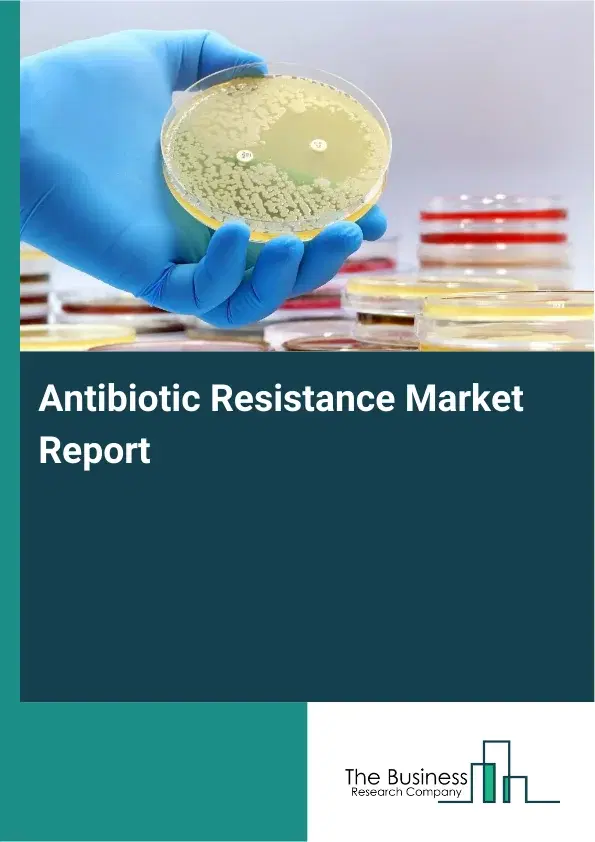
Global Antibiotic Resistance Market Report 2026

Antibiotic Resistance Market Report 2026
Global Outlook – By Drug Class (Beta Lactum Antibiotic, Cephalosporins, Quinolones Antibiotics, Macrolide Antibiotics, Tetracyclines, Oxazolidinones, Other Drug Classes), By Pathogen (Staphylococcus Aureus, Staphylococcus Pneumonia, Neisseria Gonorrhoeae, Enterococcus Faecium, Escherichia Coli, Klebsiella Pneumonia, Shigella, Clostridium Difficile, Other Pathogens), By Disease Type (Urinary Tract Infection, Intra-Abdominal Infection, Blood Stream infections, Clostridium Difficile Infections, Other Disease Types), By Mechanism Of Action (Protein Synthesis Inhibitors, Cell Wall Synthesis Inhibitors, RNA Synthesis Inhibitors, DNA Synthesis Inhibitors, Other Mechanism Of Actions), By End Users (Hospitals, Homecare, Specialty Clinics, Other End-users) - Market Size, Trends, And Global Forecast 2026-2035
Antibiotic Resistance Market Overview
• Antibiotic Resistance market size has reached to $12.85 billion in 2025 • Expected to grow to $18.22 billion in 2030 at a compound annual growth rate (CAGR) of 7.3% • Growth Driver: The Impact Of Rising Drug-Resistant Infections On The Antibiotic Resistance Market • Market Trend: Product Innovations In The Antibiotic Resistance Market • North America was the largest region in 2025 and Asia-Pacific is the fastest growing region.What Is Covered Under Antibiotic Resistance Market?
Antimicrobial resistance is a condition that occurs when microorganisms such as bacteria and fungi gain the capacity to resist medications that are meant to kill them. Resistance to infections is challenging to treat, leading to the death of an infected individual in the worst cases. The main antibiotic-resistance drug classes are beta-lactam antibiotics, cephalosporins, quinolone antibiotics, macrolide antibiotics, tetracyclines, oxazolidinones, and others. Beta-lactam antibiotics are antibiotics containing a beta-lactam ring in their chemical structure that is used to prevent bacterial cell wall construction by covalently attaching to key penicillin-binding proteins (PBPs) that inhibit the growth of organisms. The various pathogens include staphylococcus aureus, staphylococcus pneumonia, Neisseria gonorrhoeae, enterococcus faecium, escherichia coli, klebsiella pneumonia, shigella, Clostridium difficile, and others that are used during diseases such as urinary tract infection, intra-abdominal infection, bloodstream infections, clostridium difficile infections, and others. The various mechanisms include protein synthesis inhibitors, cell wall synthesis inhibitors, RNA synthesis inhibitors, DNA synthesis inhibitors, and others that are used by different end users such as hospitals, homecare, specialty clinics, and others.
What Is The Antibiotic Resistance Market Size and Share 2026?
The antibiotic resistance market size has grown strongly in recent years. It will grow from $12.85 billion in 2025 to $13.73 billion in 2026 at a compound annual growth rate (CAGR) of 6.8%. The growth in the historic period can be attributed to widespread antibiotic misuse, increasing hospital-acquired infections, expansion of broad-spectrum antibiotic use, limited availability of novel antibiotics, rising prevalence of resistant pathogens.What Is The Antibiotic Resistance Market Growth Forecast?
The antibiotic resistance market size is expected to see strong growth in the next few years. It will grow to $18.22 billion in 2030 at a compound annual growth rate (CAGR) of 7.3%. The growth in the forecast period can be attributed to increasing investments in antimicrobial R&D, growing adoption of precision diagnostics, expansion of global resistance surveillance networks, rising focus on alternative therapies, increasing public-private partnerships. Major trends in the forecast period include increasing focus on novel antibiotic development, rising adoption of combination drug therapies, growing use of rapid diagnostic testing, expansion of antimicrobial stewardship programs, enhanced surveillance of resistant pathogens.Global Antibiotic Resistance Market Segmentation
1) By Drug Class: Beta Lactum Antibiotic, Cephalosporins, Quinolones Antibiotics, Macrolide Antibiotics, Tetracyclines, Oxazolidinones, Other Drug Classes 2) By Pathogen: Staphylococcus Aureus, Staphylococcus Pneumonia, Neisseria Gonorrhoeae, Enterococcus Faecium, Escherichia Coli, Klebsiella Pneumonia, Shigella, Clostridium Difficile, Other Pathogens 3) By Disease Type: Urinary Tract Infection, Intra-Abdominal Infection, Blood Stream infections, Clostridium Difficile Infections, Other Disease Types 4) By Mechanism Of Action: Protein Synthesis Inhibitors, Cell Wall Synthesis Inhibitors, RNA Synthesis Inhibitors, DNA Synthesis Inhibitors, Other Mechanism Of Actions 5) By End Users: Hospitals, Homecare, Specialty Clinics, Other End-users Subsegments: 1) By Beta Lactam Antibiotics: Penicillins, Cephalosporins, Carbapenems, Monobactams 2) By Cephalosporins: First-generation, Second-generation, Third-generation, Fourth-generation 3) By Quinolones Antibiotics: Fluoroquinolones, Other Quinolones 4) By Macrolide Antibiotics: Erythromycin, Azithromycin, Clarithromycin 5) By Tetracyclines: Doxycycline, Minocycline, Tetracycline 6) By Oxazolidinones: Linezolid, Tedizolid 7) By Other Drug Classes: Glycopeptides, Lipopeptides, Streptogramins, PolymyxinsWhat Is The Driver Of The Antibiotic Resistance Market?
The prevalence of drug-resistant infections is expected to propel the growth of the antibiotic-resistance market going forward. Drug-resistant infections are diseases caused by resistant bacteria, resulting in an infection that is far more difficult or impossible to cure. Antimicrobial resistance drugs help treat various drug-resistant infections with improved antibiotic treatment outcomes concerning both target and nontarget pathogens, dependent on the details of resistance mechanisms and microbiome community interaction structure. For instance, in November 2025, according to the UK Health Security Agency, a UK-based government agency responsible for all health security in England, the number of deaths among individuals with antibiotic-resistant infections rose from 2,041 in 2023 to 2,379 in 2024, reflecting an increase of 338 deaths over the course of a single year. Therefore, the prevalence of drug-resistant infections is driving the antibiotic resistance industry.Key Players In The Global Antibiotic Resistance Market
Major companies operating in the antibiotic resistance market are Pfizer Inc., Johnson and Johnson, F. Hoffmann-La Roche Ltd, AbbVie Inc., Novartis AG, Merck and Co. Inc., Bristol-Myers Squibb, Sanofi S.A., AstraZeneca, GlaxoSmithKline Plc, Eli Lilly and Company, Boehringer Ingelheim International GmbH, Astellas Pharma, Daiichi Sankyo, Chugai Pharmaceutical Co. Ltd., Teva Pharmaceutical Industries Ltd., Paratek Pharmaceuticals Inc., Basilea Pharmaceutica Ltd., Theravance Biopharma Inc., Nabriva Therapeutics Plc, Seres Therapeutics Inc., Armata Pharmaceuticals Inc.Global Antibiotic Resistance Market Trends and Insights
Major companies operating in the antibiotic resistance market are focusing on developing innovative products to enhance treatment efficacy, ensure patient safety, and address the growing challenge of multi-drug resistant (MDR) infections. For instance, in January 2023, Alkem Laboratories Limited, an India-based pharmaceutical company, introduced Zidavi, a novel antibiotic designed to combat MDR infections, improving availability, affordability, and accessibility while saving the lives of critically ill patients. Zidavi is a unique combination of ceftazidime and avibactam that can treat infections caused by MDR gram-negative pathogens. Available as a sterile powdered concentrate for reconstitution, each single-dose vial contains ceftazidime pentahydrate equivalent to 2 g ceftazidime and avibactam sodium equivalent to 0.5 g avibactam. It provides an effective alternative for treating hospital-acquired pneumonia (HAP) and severe intra-abdominal infections (IAIs) caused by meropenem- and colistin-resistant pathogens.What Are Latest Mergers And Acquisitions In The Antibiotic Resistance Market?
In June 2024, Eli Lilly and Co., a US-based pharmaceutical company that provides antimicrobial resistance, partnered with OpenAI to advance healthcare through AI-driven innovation. Through this partnership, Lilly aims to accelerate the discovery and development of medicines targeting drug-resistant bacteria by leveraging OpenAI’s generative AI technologies and enhancing its technological capabilities in antimicrobial research. OpenAI is a US-based provider of artificial intelligence technologies and generative AI solutions.Regional Outlook
North America was the largest region in the antibiotic resistance market in 2025. Asia-Pacific is expected to be the fastest-growing region in the forecast period. The regions covered in this market report are Asia-Pacific, South East Asia, Western Europe, Eastern Europe, North America, South America, Middle East, Africa. The countries covered in this market report are Australia, Brazil, China, France, Germany, India, Indonesia, Japan, Taiwan, Russia, South Korea, UK, USA, Canada, Italy, Spain.What Defines the Antibiotic Resistance Market?
The antibiotic resistance market consists of sales of antibiotic drug classes such as carbapenems, glycopeptide antibiotics, penicillin, fluoroquinolones, trimethoprim-sulfamethoxazole, lincosamides, aminoglycosides, polymyxins, and nitroimidazoles. Values in this market are ‘factory gate’ values, that is the value of goods sold by the manufacturers or creators of the goods, whether to other entities (including downstream manufacturers, wholesalers, distributors, and retailers) or directly to end customers. The value of goods in this market includes related services sold by the creators of the goods.How is Market Value Defined and Measured?
The market value is defined as the revenues that enterprises gain from the sale of goods and/or services within the specified market and geography through sales, grants, or donations in terms of the currency (in USD unless otherwise specified). The revenues for a specified geography are consumption values that are revenues generated by organizations in the specified geography within the market, irrespective of where they are produced. It does not include revenues from resales along the supply chain, either further along the supply chain or as part of other products.What Key Data and Analysis Are Included in the Antibiotic Resistance Market Report 2026?
The antibiotic resistance market research report is one of a series of new reports from The Business Research Company that provides market statistics, including industry global market size, regional shares, competitors with the market share, detailed market segments, market trends and opportunities, and any further data you may need to thrive in the antibiotic resistance industry. The market research report delivers a complete perspective of everything you need, with an in-depth analysis of the current and future state of the industry.Antibiotic Resistance Market Report Forecast Analysis
| Report Attribute | Details |
|---|---|
| Market Size Value In 2026 | $13.73 billion |
| Revenue Forecast In 2035 | $18.22 billion |
| Growth Rate | CAGR of 6.8% from 2026 to 2035 |
| Base Year For Estimation | 2025 |
| Actual Estimates/Historical Data | 2020-2025 |
| Forecast Period | 2026 - 2030 - 2035 |
| Market Representation | Revenue in USD Billion and CAGR from 2026 to 2035 |
| Segments Covered | Drug Class, Pathogen, Disease Type, Mechanism Of Action, End Users |
| Regional Scope | Asia-Pacific, Western Europe, Eastern Europe, North America, South America, Middle East, Africa |
| Country Scope | The countries covered in the report are Australia, Brazil, China, France, Germany, India, ... |
| Key Companies Profiled | Pfizer Inc., Johnson and Johnson, F. Hoffmann-La Roche Ltd, AbbVie Inc., Novartis AG, Merck and Co. Inc., Bristol-Myers Squibb, Sanofi S.A., AstraZeneca, GlaxoSmithKline Plc, Eli Lilly and Company, Boehringer Ingelheim International GmbH, Astellas Pharma, Daiichi Sankyo, Chugai Pharmaceutical Co. Ltd., Teva Pharmaceutical Industries Ltd., Paratek Pharmaceuticals Inc., Basilea Pharmaceutica Ltd., Theravance Biopharma Inc., Nabriva Therapeutics Plc, Seres Therapeutics Inc., Armata Pharmaceuticals Inc. |
| Customization Scope | Request for Customization |
| Pricing And Purchase Options | Explore Purchase Options |